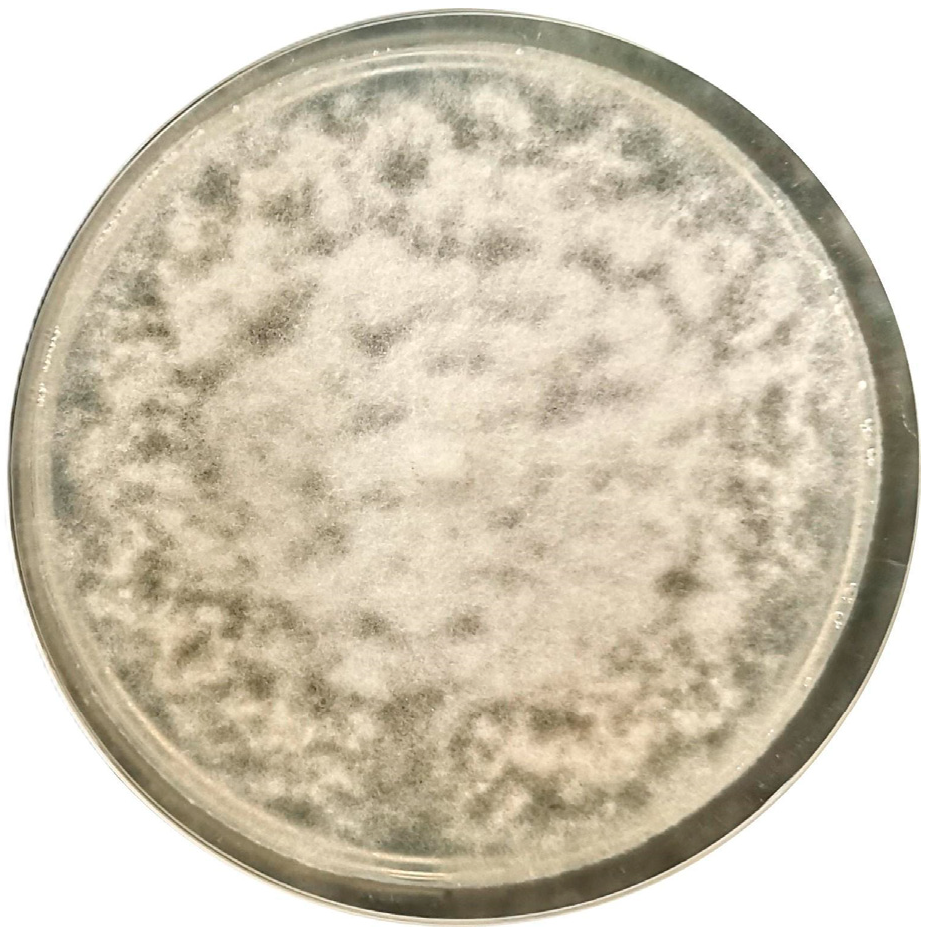
Pathogens 14 00960 g001 Pathogens 14 00960 g001

Isolation and Characterization of Globisporangium glomeratum (syn. Pythium glomeratum) from Declining Holm Oak in a Historical Garden
Abstract
1. Introduction
2. Materials and Methods
3. Results and Discussion
Author Contributions
Funding
Institutional Review Board Statement
Informed Consent Statement
Data Availability Statement
Conflicts of Interest
References
- Carrari, E.; Aglietti, C.; Bellandi, A.; Dibari, C.; Ferrini, F.; Fineschi, S.; Galeotti, P.; Giuntoli, A.; Manganelli Del Fa, R.; Moriondo, M.; et al. The management of plants and their impact on monuments in historic gardens: Current threats and solutions. Urban For. Urban Green. 2022, 76, 127727. [Google Scholar] [CrossRef]
- Ciaffi, M.; Alicandri, E.; Vettraino, A.M.; Paolacci, A.R.; Tamantini, M.; Tomao, A.; Agrimi, M.; Kuzminsky, E. Conservation of Veteran Trees within Historical Gardens (COVE): A case study applied to Platanus orientalis L. in Central Italy. Urban For. Urban Green. 2018, 34, 336–347. [Google Scholar] [CrossRef]
- Cunha, A.R.; Soares, A.L.; Catarino, S.; Duarte, M.C.; Romeiras, M.M. Assessing the vulnerability of urban tree species to climate change: The case study of Lisbon gardens. Urban For. Urban Green. 2025, 104, 128664. [Google Scholar] [CrossRef]
- Vettraino, A.M.; Soulioti, N.; Matosevic, D.; Tuğba Doğmuş Lehtijarvi, H.; Woodward, S.; Santini, A.; Luchi, N. Management of fungal diseases of Platanus under changing climate conditions: Case studies in urban areas. Urban For. Urban Green. 2025, 107, 128750. [Google Scholar] [CrossRef]
- Antonelli, C.; Soulioti, N.; Linaldeddu, B.T.; Tsopelas, P.; Biscontri, M.; Tsoukas, C.; Paplomatas, E.; Kuzminsky, E.; Vettraino, A.M. Phytophthora nicotianae and Ph. mediterranea: A Biosecurity threat to Platanus orientalis and P. x acerifolia in urban green areas in Greece. Urban For. Urban Green. 2024, 95, 128281. [Google Scholar] [CrossRef]
- Khdiar, M.Y.; Barber, P.A.; Hardy, G.E.S.; Shaw, C.; Steel, E.J.; McMains, C.; Burgess, T.I. Association of Phytophthora with declining vegetation in an urban forest environment. Microorganisms 2020, 8, 973. [Google Scholar] [CrossRef]
- Tkaczyk, M.; Sikora, K. First report of the occurrence of Phytophthora honggalleglyana in an urban green space in Poland. Urban For. Urban Green. 2025, 108, 128834. [Google Scholar] [CrossRef]
- Vettraino, A.M.; Matošević, D. Sustainable management strategies for enhancing urban tree health and resilience. Urban For. Urban Green. 2025, 128859. [Google Scholar] [CrossRef]
- Dale, A.G.; Frank, S.D. Warming and drought combine to increase pest insect fitness on urban trees. PLoS ONE 2017, 12, e0173844. [Google Scholar] [CrossRef]
- Franić, I.; Cleary, M.; Aday Kaya, A.G.; Bragança, H.; Brodal, G.; Cech, T.L.; Chandelier, A.; Doğmuş-Lehtijärvi, T.; Eschen, R.; Lehtijärvi, A.; et al. The biosecurity risks of international forest tree seed movements. Curr. For. Rep. 2023, 10, 89–102. [Google Scholar] [CrossRef]
- Marcot, B.G.; Scott, P.; Burgess, T.I. Multivariate Bayesian analysis to predict invasiveness of Phytophthora pathogens. Eco-sphere 2023, 14, e4573. [Google Scholar] [CrossRef]
- Schiffer-Forsyth, K.; Frederickson Matika, D.F.; Hedley, P.E.; Cock, P.J.A.; Green, S. Phytophthora in horticultural nursery green waste—A Risk to Plant Health. Horticulturae 2023, 9, 616. [Google Scholar] [CrossRef]
- Weed, A.S.; Ayres, M.P.; Hicke, J.A. Consequences of climate change for biotic disturbances in North American forests. Ecol. Monogr. 2013, 83, 441–470. [Google Scholar] [CrossRef]
- Avan, M.; Palacioğlu, G.; Sarigül Ertek, T.; Katircioğlu, Y.Z.; Bayraktar, H.; Kaya, R.; Maden, S. Sugar beet root rot caused by oomycetous pathogens in Turkey and their control by seed treatment. Turk. J. Agric. For. 2020, 44, 631–641. [Google Scholar] [CrossRef]
- Ertek, T.S.; Bayraktar, H. pathogenic oomycota species in walnut nurseries of Bursa and Isparta(Eğirdir) provinces in Türkiye, with a first report of Phytopythium vexans, Phytopythium litorale, Pythium aphanidermatum and Globisporangium ultimum on walnut. Physiol. Mol. Plant Pathol. 2025, 139, 102809. [Google Scholar] [CrossRef]
- Kimura, M. A Simple method for estimating evolutionary rates of base substitutions through comparative studies of nucleotide sequences. J. Mol. Evol. 1980, 16, 111–120. [Google Scholar] [CrossRef]
- Tamura, K.; Stecher, G.; Kumar, S. MEGA11: Molecular evolutionary genetics analysis version 11. Mol. Biol. Evol. 2021, 38, 3022–3027. [Google Scholar] [CrossRef]
- Uzuhashi, S.; Kakishima, M.; Tojo, M. Phylogeny of the genus Pythium and description of new genera. Mycoscience 2010, 51, 337–365. [Google Scholar] [CrossRef]
- Villa, N.O.; Kageyama, K.; Asano, T.; Suga, H. Phylogenetic relationships of Pythium and Phytophthora species based on ITS rDNA, Cytochrome Oxidase II and -Tubulin Gene Sequences. Mycologia 2006, 98, 410–422. [Google Scholar] [CrossRef]
- Paul, B. Pythium glomeratum, a New species isolated from agricultural soil taken in North-Eastern France, its ITS region and its comparison with related species. FEMS Microbiol. Lett. 2003, 225, 47–52. [Google Scholar] [CrossRef]
- Feng, H.; Chen, J.; Yu, Z.; Li, K.; Li, Z.; Li, Y.; Sun, Z.; Wang, Y.; Ye, W.; Zheng, X. Pathogenicity and fungicide sensitivity of Pythium and Phytopythium Spp. Associated with Soybean in the Huang-Huai Region of China. Plant Pathol. 2020, 69, 1083–1092. [Google Scholar] [CrossRef]
- Rojas, J.A.; Jacobs, J.L.; Napieralski, S.; Karaj, B.; Bradley, C.A.; Chase, T.; Esker, P.D.; Giesler, L.J.; Jardine, D.J.; Malvick, D.K.; et al. Oomycete Species Associated with Soybean Seedlings in North America—Part I: Identification and pathogenicity characterization. Phytopathology® 2017, 107, 280–292. [Google Scholar] [CrossRef]
- Derviş, S.; Özer, G.; Türkölmez, Ş.; Çiftçi, O. First report of Globisporangium heterothallicum causing root and crown rot of pepper in Turkey. New Dis. Rep. 2020, 41, 36. [Google Scholar] [CrossRef]
- Moorman, G.W.; Kang, S.; Geiser, D.M.; Kim, S.H. Identification and characterization of Pythium species associated with greenhouse floral crops in Pennsylvania. Plant Dis. 2002, 86, 1227–1231. [Google Scholar] [CrossRef] [PubMed]
- Lazreg, F.; Belabid, L.; Sánchez, J.; Gallego, E. Root rot and damping-off of Aleppo pine seedlings caused by Pythium spp. in Algerian forest nurseries. J. For. Sci. 2016, 62, 322–328. [Google Scholar] [CrossRef]
- Antonelli, C.; Biscontri, M.; Tabet, D.; Vettraino, A.M. The never-ending presence of Phytophthora species in Italian nurseries. Pathogens 2022, 12, 15. [Google Scholar] [CrossRef]
- Cleary, M.; Oskay, F.; Doğmuş, H.T.; Lehtijärvi, A.; Woodward, S.; Vettraino, A.M. Cryptic risks to forest biosecurity as-sociated with the global movement of commercial seed. Forests 2019, 10, 459. [Google Scholar] [CrossRef]
- Singh, B.K.; Delgado-Baquerizo, M.; Egidi, E.; Guirado, E.; Leach, J.E.; Liu, H.; Trivedi, P. Climate change impacts on plant pathogens, food security and paths forward. Nat. Rev. Microbiol. 2023, 21, 640–656. [Google Scholar] [CrossRef]
- Bregant, C.; Carloni, F.; Borsetto, G.; Delle Donne, A.G.; Linaldeddu, B.T.; Murolo, S. Multiple Botryosphaeriaceae and Phytophthora species involved in the etiology of Holm Oak (Quercus ilex L.) Decline in Southern Italy. Forests 2025, 16, 1052. [Google Scholar] [CrossRef]
- De Sampaio E Paiva Camilo-Alves, C.; Da Clara, M.I.E.; De Almeida Ribeiro, N.M.C. Decline of Mediterranean oak trees and its association with Phytophthora cinnamomi: A Review. Eur. J. For. Res. 2013, 132, 411–432. [Google Scholar] [CrossRef]
- Jung, T.; Orlikowski, L.; Henricot, B.; Abad-Campos, P.; Aday, A.G.; Aguín Casal, O.; Bakonyi, J.; Cacciola, S.O.; Cech, T.; Chavarriaga, D.; et al. Widespread Phytophthora infestations in european nurseries put forest, semi-natural and horticultural ecosystems at high risk of Phytophthora diseases. For. Pathol. 2016, 46, 134–163. [Google Scholar] [CrossRef]
- Vettraino, A.M.; Barzanti, G.P.; Bianco, M.C.; Ragazzi, A.; Capretti, P.; Paoletti, E.; Luisi, N.; Anselmi, N.; Vannini, A. Occurrence of Phytophthora species in oak stands in Italy and their association with declining oak trees. For. Pathol. 2002, 32, 19–28. [Google Scholar] [CrossRef]

| GenBank Accession Numbers | ||||
|---|---|---|---|---|
| Species | Isolate | ITS | LSU | Cox II |
| In this study | N54 | PX275941 | PX282578 | PX308648 |
| Globisporangium heterothallicum | CBS 451.67 | AB507409 | AB513045 | AB513045 |
| G. heterothallicum | Tr.Ca01 | MT039879 | MT039885 | MT039885 |
| G. heterothallicum | Tr.Ca02 | MT039880 | MT039886 | MT039886 |
| G. rostratum | OPU1441 | AB468775 | AB468713 | AB468713 |
| G. splendens | UZ174 | AB468778 | AB468716 | AB468716 |
| Pythium glomeratum | CBS 122644 | HQ643542 | HQ665097 | HQ665097 |
| P. glomeratum | CBS 119165 | HQ643544 | HQ665085 | ---- |
| P. glomeratum | CBS 122651 | HQ643541 | HQ665104 | ---- |
| P. irregulare | UZ370 | AB468770 | AB468706 | AB468706 |
| P. nunn | UZ041 | AB468771 | AB468709 | AB468709 |
| P. spinosum | UZ150 | AB468776 | AB468714 | AB468714 |
| P. sylvaticum | UZ307 | AB468779 | AB468717 | AB468717 |
| P. ultimum | UZ056 | AB468781 | AB468719 | AB468719 |
| P. uncinulatum | Py-2 | AB468782 | AB468720 | AB468720 |
Disclaimer/Publisher’s Note: The statements, opinions and data contained in all publications are solely those of the individual author(s) and contributor(s) and not of MDPI and/or the editor(s). MDPI and/or the editor(s) disclaim responsibility for any injury to people or property resulting from any ideas, methods, instructions or products referred to in the content. |
© 2025 by the authors. Licensee MDPI, Basel, Switzerland. This article is an open access article distributed under the terms and conditions of the Creative Commons Attribution (CC BY) license (https://creativecommons.org/licenses/by/4.0/).
Share and Cite
Vettraino, A.M.; Narduzzi, M.; Antonelli, C. Isolation and Characterization of Globisporangium glomeratum (syn. Pythium glomeratum) from Declining Holm Oak in a Historical Garden. Pathogens 2025, 14, 960. https://doi.org/10.3390/pathogens14100960
Vettraino AM, Narduzzi M, Antonelli C. Isolation and Characterization of Globisporangium glomeratum (syn. Pythium glomeratum) from Declining Holm Oak in a Historical Garden. Pathogens. 2025; 14(10):960. https://doi.org/10.3390/pathogens14100960
Chicago/Turabian StyleVettraino, Anna Maria, Michele Narduzzi, and Chiara Antonelli. 2025. "Isolation and Characterization of Globisporangium glomeratum (syn. Pythium glomeratum) from Declining Holm Oak in a Historical Garden" Pathogens 14, no. 10: 960. https://doi.org/10.3390/pathogens14100960
APA StyleVettraino, A. M., Narduzzi, M., & Antonelli, C. (2025). Isolation and Characterization of Globisporangium glomeratum (syn. Pythium glomeratum) from Declining Holm Oak in a Historical Garden. Pathogens, 14(10), 960. https://doi.org/10.3390/pathogens14100960

